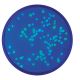
Transformation of E. coli with Green & Blue Fluorescent Proteins, Manufacturer reference: 222

Transformation of E. coli with Green Fluorescent Protein, Manufacturer reference: 223
ABOUT THIS PRODUCT:
DOWNLOAD SAMPLE INSTRUCTIONS

Details
Group Size:
For 10 lab groups
Time Required:
Set Up - 50 minutes / Incubation - overnight / Transformation - 15 minutes
Kit Includes:
Instructions, BactoBeads™ E. coli GFP Host, supercoiled pFluoroGreen™ plasmid DNA, ampicillin, IPTG, CaCl2, Growth Additive, ReadyPour™ Luria Broth Agar (sterile), Luria Broth Medium for Recovery (sterile), petri plates (small), petri plates (large), plastic microtipped transfer pipets, wrapped 10 ml pipet (sterile), toothpicks (sterile), inoculating loops (sterile), microcentrifuge tubes
All You Need:
Automatic micropipette (5-50 µl) and tips, two water baths (37ºC and 42ºC), thermometer, incubation oven (37ºC), pipet pumps or bulbs, ice, marking pens, bunsen burner, hot plate or microwave, hot gloves, long wave UV light
Storage:
Some Components Require Refrigerator and Freezer Storage
Replenisher:
- #223 FB - EDVO-Kit #223/AP08 Replenisher (Comp. B-D + Growth Additive)
- #728 - BactoBeads™ E. coli GFP Host
Resource
Quick Guides:
Troubleshooting Guides:
Safety Data Sheets:
Miscellaneous:
Instructional Videos:
| Manufacturer | Edvotek Inc. |
|---|---|
| Size / Rxns Number: | No |
| Protocol & Manual | No |
| Technical Tips | No |